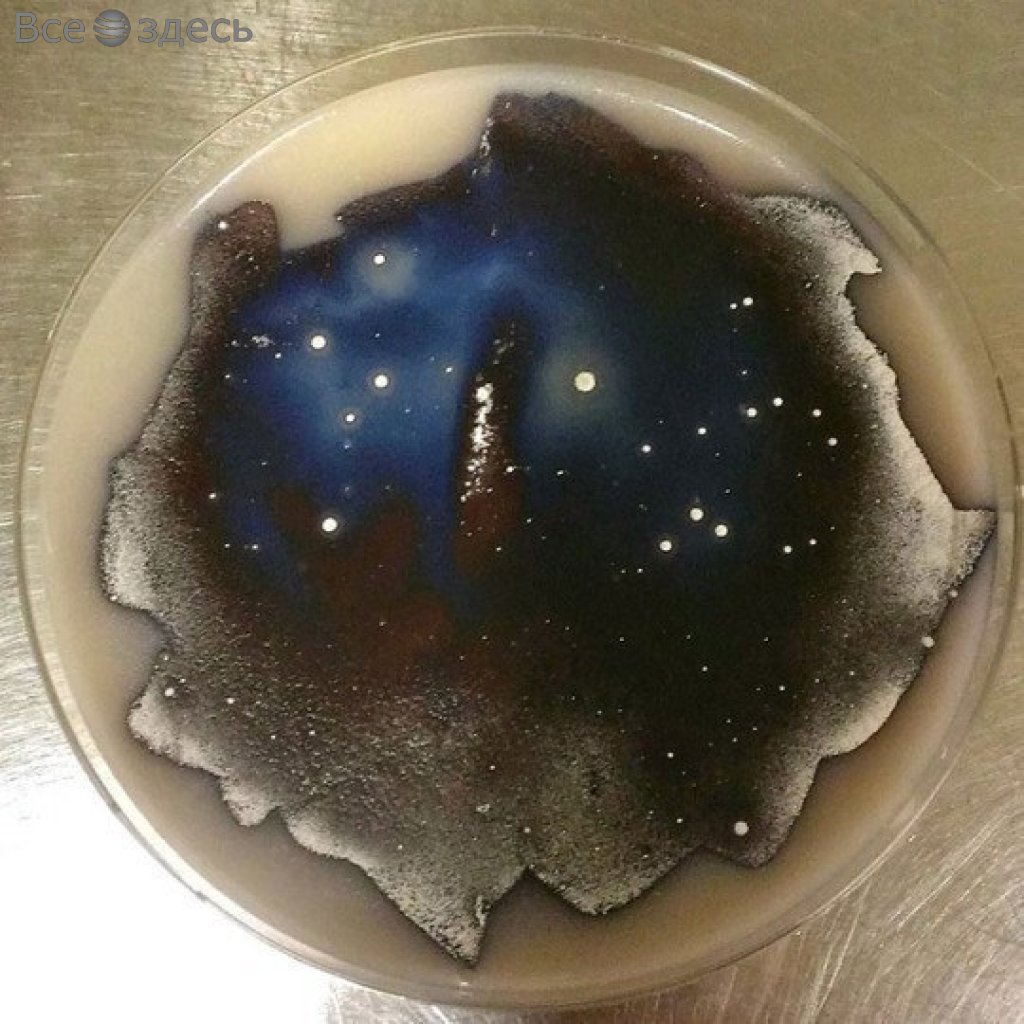
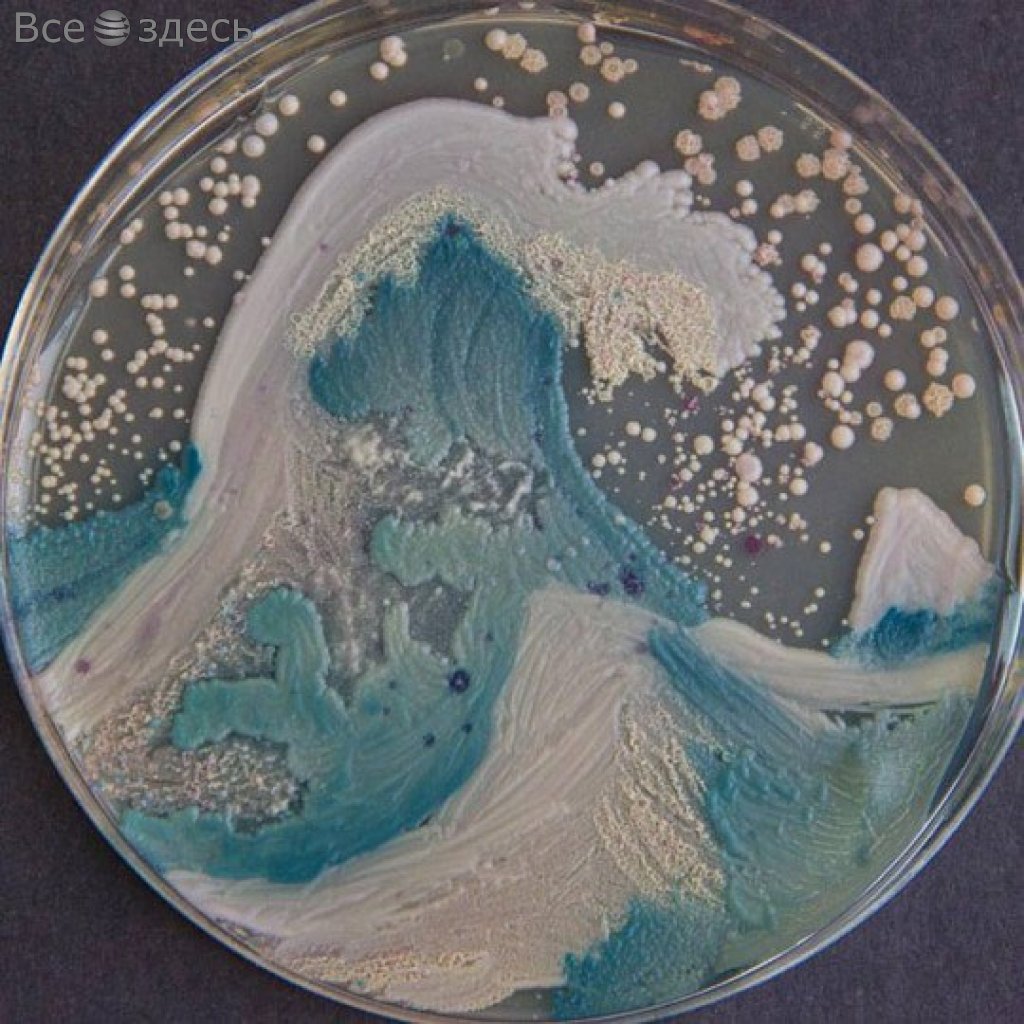

Если биологи вдруг хотят полубоваться на нечто красивое. то они решают начать рисовать прямо на чашках Петри. Правда, не красками, а прикольными разнацветными … бактериями. Какими именно – история умалчивает. При этом микробиологи даже проводят арт-конкурсы, соревнуясь, у кого же получится более красивая картина на агаре. Среди работ, которые мы решили вам показать сегодня – прикольные абстракции, снежные вершины, маленький домик, среди лесной чащи и прочие интересные сюжеты. Напоминает при первом впечатлении какие-то картины маслом. Все это – фантазия ученых, а ведь сразу и не скажешь, правда?

 Развлекалово от ученых
Развлекалово от ученых